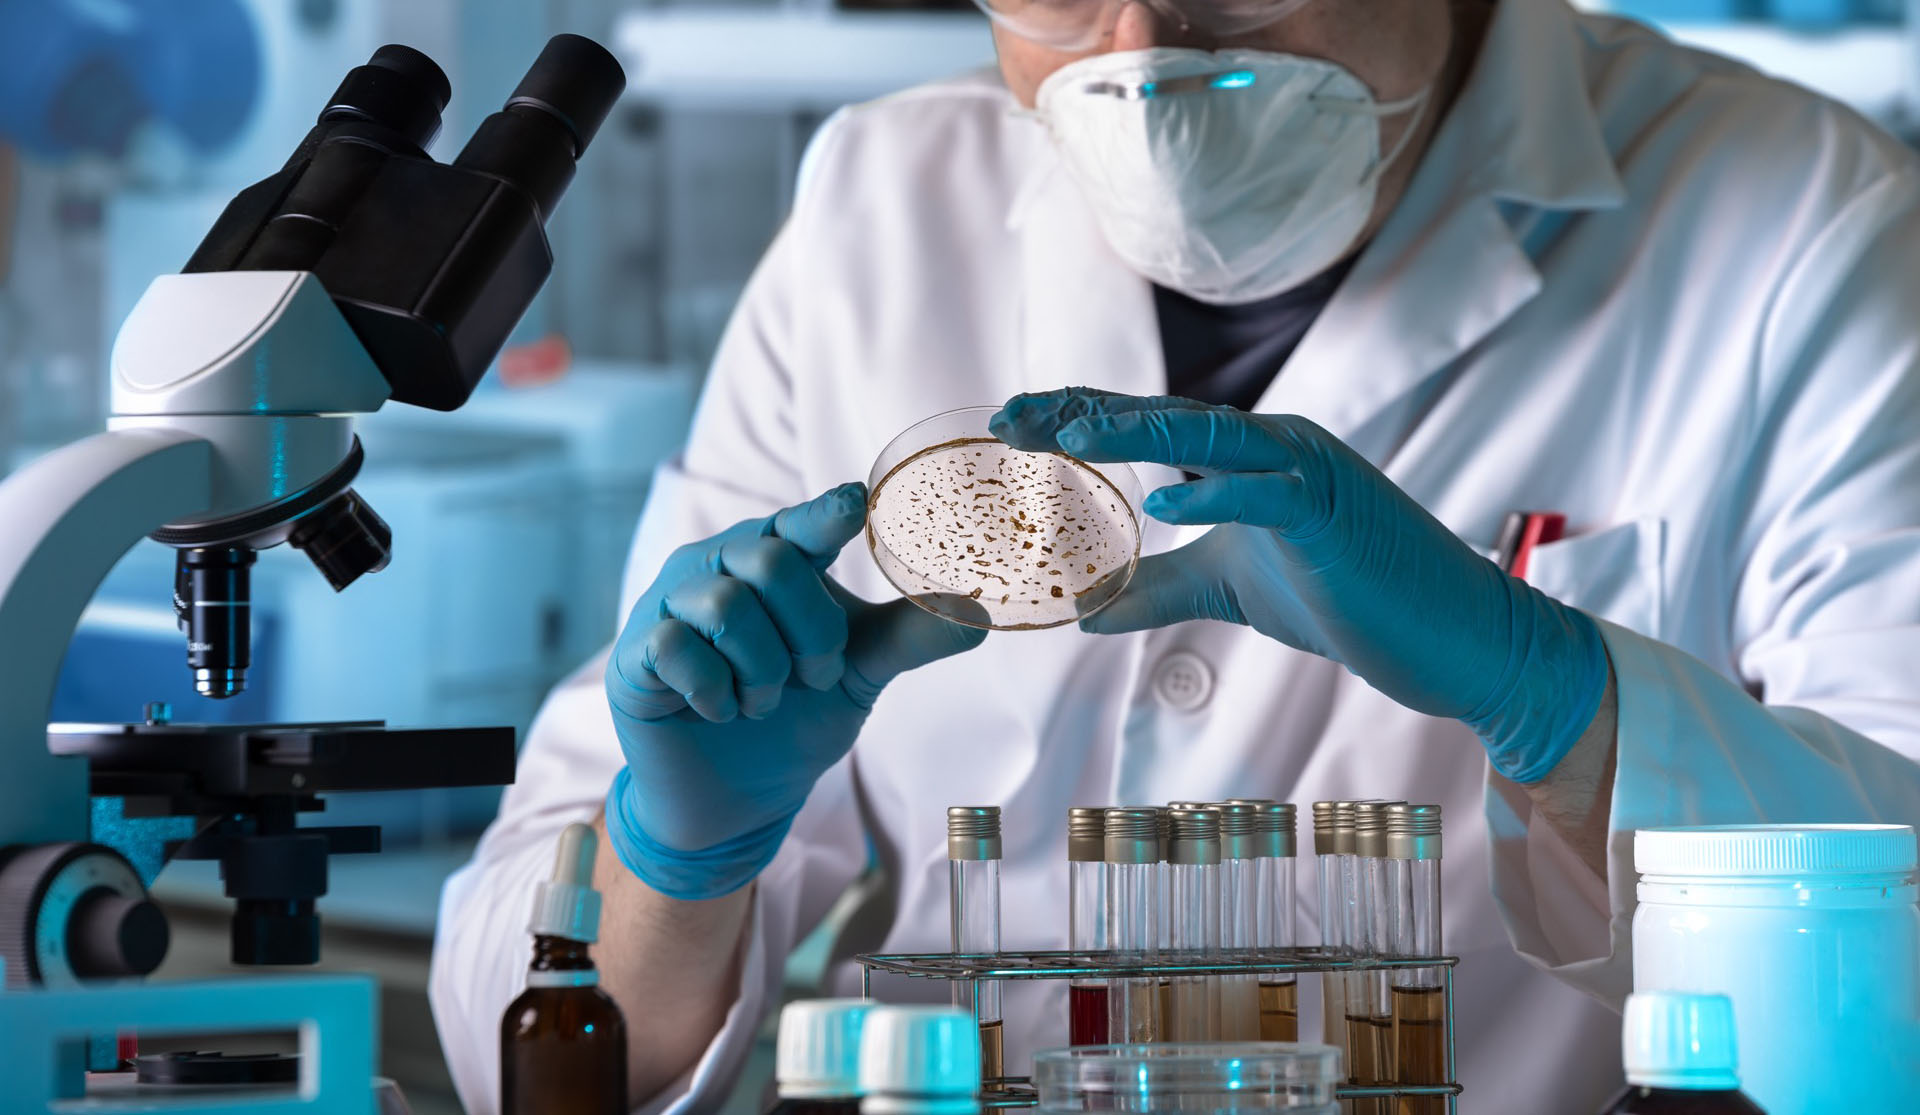

Ligne ferroviaire minière : Réalisation d’une base de vie du projet
Par : Salah Chiahi Dans le cadre plan national d’extension et de développement du réseau ferroviaire, notamment celui destiné au transport de matériaux et de marchandises; segment incontournable de la relance de l’économie nationale, Mme Houria Aggoun; wali de Guelma s’est rendue,ce mardi 20 juin à Oued-Fragha, commune relevant de la daïra de Bouchegouf pour visionner le site destiné à…
Lire plus